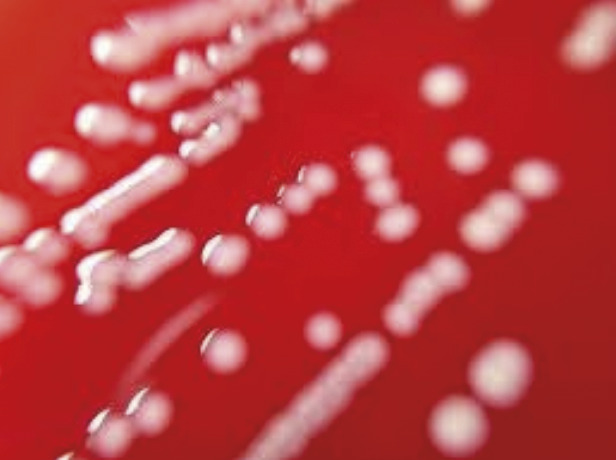
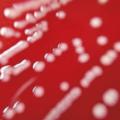

Des germes fréquents chez les animaux
Les pasteurelles sont des germes commensaux cosmopolites du tractus respiratoire supérieur des mammifères et du tube digestif des oiseaux, très répandus chez le bétail. Responsables de rhinite atrophique chez l’animal, elles entraînent d’importantes pertes économiques. Les pasteurelloses humaines surviennent après un contact avec un animal infesté.
Elles sont regroupées en cinq espèces : Pasteurella multocida, la plus importante, P. canis, P. dagmatis, P. stomatis et P. oralis. Ces coccobacilles, à Gram négatif, ont la forme d’un court bâtonnet de 1 × 0,3 μm, avec une coloration bipolaire et une capsule visible en contraste de phase. Exposées à des températures froides (4 °C) ou chaudes (56 °C), ces bactéries sont détruites.
La pathogénie est due à la toxine dermo- nécrotique isolée chez le porc. Elle provoque une rhinite atrophique, qui se manifeste par une destruction des cartilages, une ostéolyse et une hyperplasie épithéliale. Cette pathologie n’est pas constatée chez l’homme, et d’ailleurs cette toxine n’est pas retrouvée en cas de contamination par blessure.
Pasteurellose d’inoculation
Les pasteurelles sont transmises à l’homme essentiellement par les morsures et les griffures de chiens (80 %) et de chats (15 %) – accessoirement de rats, de lapins et beaucoup plus rarement d’animaux sauvages (lions, tigres) –, avec un risque fréquent de surinfection. P. multocida est responsable de la pasteurellose aviaire, ou « choléra des poules », qui provoque des diarrhées verdâtres, des tremblements et parfois la mort des volailles. Outre les cas individuels de morsure par un animal familier (
Phase aiguë
La morsure, survenant le plus souvent au niveau du membre supérieur, provoque en quelques heures une plaie inflammatoire, avec un œdème (
Phase subaiguë
Cette phase, apparaissant quelques semaines après l’inoculation, se manifeste par un œdème et des douleurs, alors que la phase aiguë a pu passer inaperçue. L’évolution est possible vers une ténosynovite des extenseurs des doigts et une arthrite inflammatoire réactionnelle des articulations proches.2 Ceci peut engendrer des séquelles fonctionnelles.3
Autres formes possibles de pasteurellose
Les pasteurelloses respiratoires apparaissent plus volontiers chez les sujets à risque (immunodépression, alcoolo-tabagisme, cancers). P. multocida est relativement fréquente dans l’oropharynx des éleveurs de porcs. Elle s’y manifeste par une angine ou une sinusite et peut évoluer vers une pneumopathie, avec un risque létal de 30 %.
Une atteinte digestive est possible (appendicite, péritonite), avec une évolution parfois fatale vers une septicémie.4 Une atteinte du système nerveux est rare, mais peut survenir après une morsure, une infection ORL, une dissémination hématogène ou post-neurochirurgicale. La forme généralisée est exceptionnelle.
Diagnostic : culture et biologie moléculaire
Le diagnostic est affirmé par la mise en évidence du bacille dans les prélèvements de sérosités au niveau de la plaie, ou éventuellement dans l’examen cytobactériologique de l’expectoration, dans le liquide céphalorachidien ou encore dans l’hémoculture.
Le prélèvement doit être ensemencé sur des milieux spéciaux, en particulier sur la gélose au sang, sachant qu’il y a souvent un polymicrobisme dû à la riche flore microbienne des cavités buccales des animaux. P. canis, P. dagmatis et P. stomatis sont exclusivement transmises par les chiens, parfois associées à P. multocida. Cette dernière acidifie le mannitol et possède une ornithine décarboxylase. Outre les cultures (
Le sérodiagnostic détecte des anticorps contre la capsule et les lipopolysaccarides, mais il est souvent positif chez les sujets en contact permanent avec les animaux.
Il faut différencier la pasteurellose de la maladie des griffes du chat, due à Bartonella henselae, qui se manifeste par une réaction érythémateuse, une fièvre et une adénopathie habituellement unique. Le diagnostic est affirmé par une sérologie.
Traitement : pénicilline
Le plus souvent, les pasteurelles isolées chez l’homme sont sensibles à la pénicilline G, l’amoxicilline, les fluoroquinolones et aux céphalines de troisième génération. Mais certaines souches isolées des bovins se sont montrées multirésistantes.
Le respect des consignes d’hygiène générale est le socle de la prévention des pasteurelloses : nettoyage et désinfection – avec blouse et gants – des locaux où sont manipulés les déchets et cadavres d’animaux, lavage des mains après contact avec les animaux. Il n’existe pas de vaccin.
En cas de plaie
Toute plaie par morsure ou griffure doit être lavée à l’eau et au savon et désinfectée par des antiseptiques. Un rappel antitétanique est nécessaire en l’absence de notion de vaccination. Une couverture antibiotique est conseillée par amoxicilline (50 mg/kg/j pendant 10 jours) ou doxycycline (200 mg/j pendant 10 jours) en cas d’allergie, ou encore par céphalosporine.
Une intervention chirurgicale est utile en cas de phlegmon des gaines. En cas de morsure importante, une chirurgie réparatrice de la main ou du visage doit être envisagée dans un second temps.
Concernant l’atteinte humaine, la pasteurellose n’est pas une maladie à déclaration obligatoire. Néanmoins, elle fait partie des maladies professionnelles indemnisables.
1. Maleb A, Elmalki J, Bouayadi O, et al. Serious phlegmonous lesion of the hand following an injury by vegetal thorn : Never forget Pasteurella multocida! Trauma Case Rep 2018;13:18-21.
2. Honnorat E, Seng P, Savini H, et al. Prosthetic joint infection caused by Pasteurella multocida : a case series and review of literature . BMC Infect Dis 2016;16:435.
3. Körmöndi S, Terhes G, Pál Z, et al. Human Pasteurellosis Health Risk for Elderly Persons Living with Companion Animals . Emerg Infect Dis 2019;25(2):229-35.
4. Ashley BD, Noone M, Dwarakanath AD, et al. Fatal Pasteurella dagmatis peritonitis and septicaemia in a patient with cirrhosis : a case report and review of the literature . J Clin Pathol 2004;57(2):210-2.
5. Lemenand O, Donnio PY. Pasteurelloses. Enc Med Chir ; Biol Med 2018;13: 1-7.